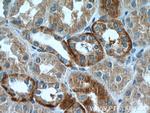
RILP Antibody in Immunohistochemistry (Paraffin) (IHC (P))

Search
Proteintech
RILP Polyclonal Antibody
{{$productOrderCtrl.translations['antibody.pdp.commerceCard.promotion.promotions']}}
{{$productOrderCtrl.translations['antibody.pdp.commerceCard.promotion.viewpromo']}}
{{$productOrderCtrl.translations['antibody.pdp.commerceCard.promotion.promocode']}}: {{promo.promoCode}} {{promo.promoTitle}} {{promo.promoDescription}}. {{$productOrderCtrl.translations['antibody.pdp.commerceCard.promotion.learnmore']}}
产品信息
13574-1-AP
种属反应
已发表种属
宿主/亚型
分类
类型
抗原
偶联物
形式
浓度
规格
纯化类型
保存液
内含物
保存条件
运输条件
产品详细信息
Immunogen sequence: ELRAGPQEE RALLRQLKEV TDRQRDELRA HNRDLRQRGQ ETEALQEQLQ RLLLVNAELR HKLAAMQTQL RAAQDRERER QQPGEAATPQ AKERARGQAG RPGHQHGQEP EWATAGAGAP GNPEDPAEAA QQLGRPSEAG QCRFSREEFE QILQERNELK AKVFLLKEEL AYFQRELLTD HRVPGLLLEA MKVAVRKQRK KIKAKMLGTP EEAESSEDEA GPWILLSDDK GDHPPPPESK IQSFFGLWYR GKAESSEDET SSPAPSKLGG EEEAQPQSPA PDPPCSALHE HLCLGASAAP EA (101-401 aa encoded by BC031621)
靶标信息
The Rab interacting lysosomal protein (RILP) is lysosomal protein that interacts with RAB7, a small GTPase that controls transport to endocytic degradative compartments. It is thought that RILP is a downstream effector of RAB7 and both proteins act together in the regulation of late endocytic traffic. Overexpression of RILP caused enlarged lysosomes that are more centrally located in the cell suggesting that RILP may also be involved in the regulation of lysosomal morphology. Other evidence suggests that RILP may play a role in the biogenesis of multivesicular bodies.
仅用于科研。不用于诊断过程。未经明确授权不得转售。
生物信息学
蛋白别名: Rab-interacting lysosomal protein; unnamed protein product
基因别名: PP10141; RILP
UniProt ID: (Human) Q96NA2
Entrez Gene ID: (Human) 83547